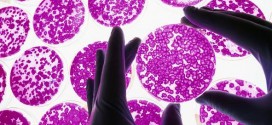
Researchers create Parkinson's disease in lab

Eminem’s ‘drugs damaged’ face, The rapper appeared thinner than we’ve ever seen him and fairly tired as he took to the podium, so what exactly has caused the changes?
Read More »World
Eric Frein court date postponed until next month, Report
Eric Frein, the subject of the 48 day manhunt in the Poconos, is not scheduled to be back in court until next month. Suspect will have his preliminary hearing in Pike County on Dec. 9.
Read More »Scotty McMillan : 3-year-old beaten to death in Pennsylvania
Scott McMillan Tortured to Death by Mother & Her Boyfriend, Jillian Tait, 31, and her boyfriend Gary Fellenbaum, 23, face murder charges in the death of her son, 3-Year-Old Scotty McMillan.
Read More »High-fat diet can delay brain aging, New Study
A high-fat diet may postpone signs of brain ageing, according to a new study which opens the possibility of novel treatments for those with Alzheimer’s and Parkinson’s disease. The research by the Center for Healthy Aging at University of Copenhagen, Denmark, and the National Institute of Health in the US studied mice having a defect in their DNA repair system.
Read More »Fat Mike kicks fan : NOFX’s punches and kicks fan who runs on stage (Video)
Fat Mike kicks fan in the face, At last night’s NoFX gig at Sydney’s Enmore Theatre, a drunk fan got a first-hand — or should that be backhand? — experience of what can happen when you jump up on stage uninvited at a punk gig. Footage from the crowd shows fan Alex hit the stage and immediately make his way …
Read More »Brad Paisley CMA joke wasn’t racist: Column
Here’s a helping of controversy to go with your country music. Before Darius Rucker took the stage, co-host Brad Paisley took a jab at the CMAs audience with a joke about ABC’s new comedy “Black-ish,” which usually airs Wednesday nights.
Read More »Researchers create Parkinson’s disease in lab
Study on rats is a ‘huge breakthrough’ which could lead to development of effective treatments. There is no cure for Parkinson’s but symptoms can be alleviated.
Read More »Canada TV Regulator bans cable cancellation periods
Canadians will no longer have to give 30 days notice to cancel their television, Internet or telephone services, the Canadian Radio-television and Telecommunications Commission announced Thursday.
Read More »No link between poor health and wind turbines, Health Canada finds
Some may find them annoying and that might cause stress, but there’s no direct link between wind turbines and human health. In the most comprehensive study of its kind in the country, Health Canada scientists looked at communities that host wind farms. Two dozen government, academic and industry experts contributed to the study.
Read More »Million Mask March marks global day of protest (Video)
The Million Mask March is sweeping the globe across Wednesday as demonstrators protest against austerity, mass surveillance and oppression. Participants will obscure their faces to protect their identity.
Read More »Hunter mauled by group of bears in Alaska (Video)
The Coast Guard has rescued a hunter injured in a bear attack in Alaska. As many as three bears attacked two men near Kodiak while they were carrying a deer they shot.
Read More » Canada Journal – News of the World Articles and videos to bring you the biggest Canadian news stories from across the country every day
Canada Journal – News of the World Articles and videos to bring you the biggest Canadian news stories from across the country every day